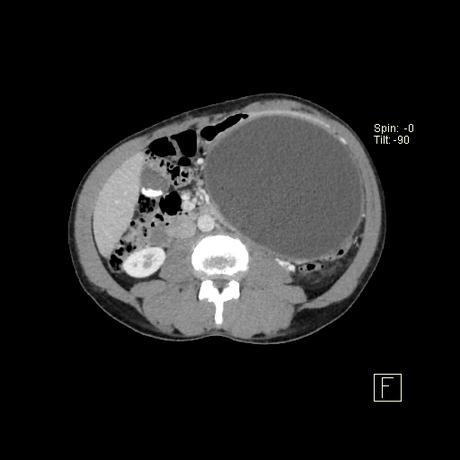
secuela común de la pancreatitis aguda

Presentación clínica
Los pseudoquistes pancreáticos se encuentran con frecuencia en el seguimiento por imágenes de la pancreatitis y pueden ser asintomáticos en sí mismos durante algún tiempo. Las presentaciones atribuibles a un seudoquiste incluyen:
efecto masivo
obstrucción biliar
Obstrucción de la salida gástrica
infección secundaria

PATOLOGIA
producen por la alteración de la estructura del conducto pancreático con la consiguiente pérdida y acumulación de jugo pancreático que da lugar a una necrosis grasa hemorrágica. No están revestidos por epitelio (por lo tanto, “pseudoquistes”), sino que una reacción inflamatoria grave da como resultado la encapsulación del quiste por tejido de granulación fibrosado. Esto suele tardar de 4 a 6 semanas 8,9 . En aproximadamente el 50% de los casos, el quiste conserva una comunicación con el conducto pancreático 2 . Estos quistes son más problemáticos de tratar y es más probable que reaparezcan.


